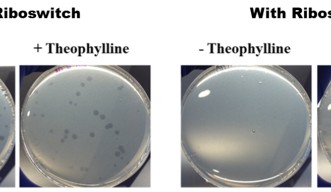

2017年10月11日
「細菌を食べる細菌」で新たな抗生物質開発をめざす
2016年、世界保健機関(WHO)は、抗生物質への耐性を「現代における健康、食の安全、そして発展にとって最大脅威のひとつ」と位置付けました。そして、現存する抗生物質に対する耐性が増していることが原因で、年々、結核や淋病などの感染症の治療が困難になっていることを報告しています。とは言え、抗生物質は人類にとって欠かせないものです。なぜなら抗生物質がなければ、感染症の蔓延に苦しむことになるからです。では、強まる耐性に警鐘を鳴らすと同時に、継続した治療を保証するための解決策は何でしょうか。
解決方法のひとつとして、病気の原因となる細菌を餌にする捕食性細菌のユニークな特性に、可能性を見出すことができます。「生きた抗生物質」と呼ばれるこの肉食類に、沖縄科学技術大学院大学(OIST)の研究者らも注目しました。この度、アメリカ化学会が発行する ACS Synthetic Biologyに掲載された論文で、微小肉食細菌、ブデロビブリオ・バクテリオヴォルスの遺伝子操作に向けた研究成果がOIST研究員らによって報告されました。この中で研究チームは、細菌の捕食特性に作用する遺伝子操作を可能にする技術について発表しています。
「将来は、細菌の捕食のタイミングと範囲を制御できるようにしたいのです。」本研究論文の筆頭著者で、OIST核酸化学・工学ユニットのモハメド・ドゥイダール博士は説明します。「しかし今のところ、それを実現するための基本的な遺伝子操作技術がないのです。」
ブデロビブリオ・バクテリオヴォルスは、人間にとっては無害な細菌ですが、大腸菌やサルモネラ菌、レジオネラ菌などの病原菌のように、悪性のグラム陰性菌と呼ばれる捕食対象を死滅させます。よって、捕食性細菌をうまく制御することで、多くの感染病を治療できる可能性があります。ただ、その独特な捕食特性や他の性質のため、これまでに行われてきたブデロビブリオ・バクテリオヴォルスの遺伝子操作は限定的なものでした。
OISTの研究者らは、ブデロビブリオ・バクテリオヴォルスの捕食特性を理解し、そして制御するため、他の細菌内で優れた働きすることで知られるリボスイッチという、遺伝子発現を制御する機能を利用しました。遺伝子発現の過程では、まずDNAがRNAに転写されます。次にRNAがタンパク質に翻訳され、そして、そのタンパク質が細胞の中でさまざまな仕事を行います。リボスイッチはこの翻訳にかかわり、RNA鎖の始まりの部分にリボスイッチを配置し、化学物質で「活性化」させると、RNAがタンパク質に翻訳されるのを開始したり抑制させたりすることが可能になるのです。
本研究で、OISTの研究員らは、ブデロビブリオ・バクテリオヴォルスの捕食特性に重要だと思われる遺伝子の1つ、鞭毛シグマ因子fliA にリボスイッチを挿入しました。そして、テオフィリンという化合物でリボスイッチを活性化しました。リボスイッチを挿入したブデロビブリオ・バクテリオヴォルスを、栄養分の豊富な大腸菌の餌とともにシャーレに入れると、テオフィリンでの活性化がされない場合と比べると、数倍も早く増殖することが観察できました。この増殖の速度は、ブデロビブリオ・バクテリオヴォルスが、餌をより速く捕食していたということを示し、その結果、増殖のスピードも加速したのです。このことは、捕食バクテリアの周期はテオフィリンによって制御できるということを示しています。
「生きた抗生物質」の開発という最終目標に加えて、本研究では容易に制御可能なブデロビブリオ・バクテリオヴォルス細胞の、さらなる活用方法も期待されています。ドゥイダール博士は化学成分を一切含まない有機栽培において、「この捕食バクテリアは、いくつかの植物病害に対し、抗菌剤にとって代わる安全な代用品となり得る可能性があります。さらに、例えば水処理施設などの産業応用も活用することができるかもしれません。」と付け加えます。
「将来は、食中毒を防ぐために、これらの捕食性細菌を新鮮な食品にスプレーして使えるようになるかもしれません」と、本研究を率いた横林洋平准教授もコメントします。
OIST研究員らによる本研究成果を踏まえた次なるステップは、ブデロビブリオ・バクテリオヴォルスが持つ抗生物質としての潜在性を十分に引き出すため、その全容を明らかにし、制御を可能とする技術について、さらなる研究を進めることです。